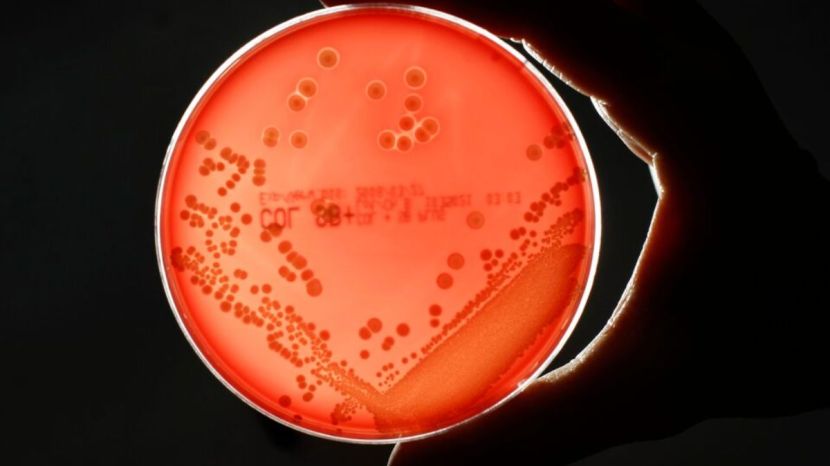

अँटिबायोटिक्सचा शोध हा वैद्यकीय विश्वातील क्रांतिकारक शोध मानला जातो. मात्र, आता हाच शोध माणसासाठी जीवघेणा ठरतोय, असे एका अहवालातून समोर आले आहे. सुरुवातीच्या काळात माणसाला एखादी दुखापत झाल्यास, आजारी पडल्यास त्यातून बरे होण्यासाठी उपचार नव्हते. मात्र, अँटिबायोटिक्स आल्यापासून प्रत्येक आजारासाठी आज अँटिबायोटिक्सच्या स्वरूपात औषधे उपलब्ध आहेत. परंतु, आरोग्यासाठी वरदान ठरणारी हीच औषधे जगासमोर आरोग्याला आव्हानही उभे करत आहेत. नवीन जागतिक विश्लेषणानुसार, अँटिमायक्रोबायल रेझिस्टन्स म्हणजे ‘एएमआर’मुळे पुढील २५ वर्षांमध्ये जवळपास चार कोटी लोकांचा मृत्यू होईल, अशी माहिती आहे
अभ्यासात असे आढळून आले आहे की, लसीकरण आणि स्वच्छतेतील प्रगतीमुळे लहान मुलांमध्ये अँटिबायोटिक्समुळे होणाऱ्या संबंधित मृत्यूचे प्रमाण कमी होत आहे; परंतु वयस्कांमध्ये हा कल उलट असल्याचे चित्र आहे. ‘एएमआर’च्या जागतिक प्रभावाचा मागोवा घेण्यासाठी करण्यात आलेले हे पहिलेच संशोधन आहे. या संशोधनात नक्की काय आढळून आले आहे? नक्की हा आजार काय आहे आणि ही समस्या किती भीषण आहे? त्याविषयी जाणून घेऊ.

हेही वाचा : New Covid XEC Variant : जगभरात वेगाने पसरतोय करोनाचा नवा विषाणू; हा विषाणू किती संसर्गजन्य अन् किती घातक?
एएमआर म्हणजे काय?
अँटिबायोटिक्सच्या चुकीच्या किंवा अतिवापरामुळे अँटिमायक्रोबायल रेझिस्टन्स म्हणजेच ‘एएमआर’ची समस्या उद्भवते. त्यालाच सुपरबग्स म्हणूनही ओळखले जाते. सुपरबग्समुळे दरवर्षी प्राण गमावणाऱ्यांची संख्या लाखोंच्या घरात आहे. शरीरातील जीवाणू, विषाणू, बुरशी व पॅरासाइट्स वेळेनुसार बदलत असतात आणि या बदलांवेळी औषधांचा त्यांच्यावर काहीही परिणाम होत नाही. त्याच वेळी अँटिमायक्रोबायल रेझिस्टन्स (एएमआर) निर्माण होतात. या स्थितीत संसर्गावर उपचार करणे कठीण होते. ही एक नैसर्गिक प्रक्रिया आहे, जी संथपणे सुरू असते. परंतु, माणूस, प्राणी व वनस्पतींमध्ये औषधांचा, विशेषत: अँटिबायोटिक्सचा अतिरेक आणि अनावश्यक वापर केल्याने ही प्रक्रिया वेगवान होत आहे. अभ्यासाचे लेखक, युनिव्हर्सिटी ऑफ वॉशिंग्टन इन्स्टिट्यूट ऑफ हेल्थ मेट्रिक्स (IHME)मधील डॉ. मोहसेन नागवी एका निवेदनात म्हणाले, “अँटीमायक्रोबियल औषधे आधुनिक आरोग्य सेवेचा एक आधारस्तंभ आहेत आणि त्यांना वाढता प्रतिकार हे चिंतेचे प्रमुख कारण आहे.“
हे संकट किती मोठे आहे?
लॅन्सेटमध्ये प्रकाशित झालेला हा अभ्यास ग्लोबल रिसर्च ऑन अँटीमायक्रोबियल रेझिस्टन्स (ग्रॅम) प्रोजेक्टने केला आहे. संशोधकांनी १९९० ते २०२१ पर्यंत झालेले मृत्यू आणि २०५० पर्यंतच्या मृत्यूंच्या अंदाजाची माहिती घेण्यासाठी २०४ देशांमधील ५२० दशलक्ष वैयक्तिक रेकॉर्डमधील डेटाचा वापर करण्यात आला आहे. संशोधकांनी २२ रोगजनक (पॅथोजेन), ८४ औषधे व रोगजनकांचे संयोजन आणि ११ संसर्गजन्य आजार, जसे की मेंदुज्वर; यांच्या उपलब्ध डेटाचा आढावा घेतला आहे. अभ्यासानुसार, १९९० ते २०२१ या काळात जगभरातील १० लाखांहून अधिक लोकांचा सुपरबग्समुळे मृत्यू झाल्याचे आढळून आले आहे.
गेल्या तीन दशकांमध्ये सुपरबग्समुळे पाच वर्षांखालील मुलांच्या मृत्यूचे प्रमाण ५० टक्क्यांहून अधिक प्रमाणात कमी झाले आहे. लहान मुलांमधील संसर्ग रोखण्यासाठी आणि तो नियंत्रित करण्यासाठी उपाययोजनेत सुधारणा केली गेल्यामुळे या प्रमाणात घट झाली आहे. परंतु, जेव्हा मुलांमध्ये सुपरबग्स उद्भवतो, तेव्हा त्यांच्यावर उपचार करणे खूप कठीण होते, असेही संशोधकांचे म्हणणे आहे. याच संशोधनात वृद्ध लोकसंख्येला संसर्ग होण्याचा धोका अधिक असल्याचे आढळून आले आहे. ७० पेक्षा जास्त वयाच्या लोकांमध्ये हे प्रमाण ८० टक्क्यांहून अधिक आहे. २०१९ च्या तुलनेत २०२१ मध्ये एएमआर मृत्यूचे प्रमाण कमी झाले; परंतु संशोधकांनी नमूद केले आहे की, हे कदाचित कोविड-१९ नियंत्रण उपायांमुळे झाले आहे आणि ही घट काही काळच असेल.
जगासाठी ही धोक्याची घंटा आहे का?
संशोधकांनी मॉडेलिंगचा वापर करून अंदाज लावला की, सध्याचा ट्रेंड पाहता, ‘एएमआर’मुळे होणाऱ्या मृत्यूंची संख्या ६७ टक्क्यांनी वाढून २०५० पर्यंत दरवर्षी सुमारे दोन दशलक्षांपर्यंत पोहोचेल. ‘एएमआर’मुळे होणाऱ्या मृत्यूंचे वार्षिक प्रमाण ८.२ दशलक्ष आहे. त्यातही ७५ टक्क्यांनी वाढ दिसून येईल, असे संशोधकांनी सांगितले. विश्लेषणानुसार, भविष्यात बहुसंख्य मृत्यू उप-सहारा आफ्रिका, दक्षिण व पूर्व आशिया, बांगलादेश, भारत व पाकिस्तानसह दक्षिण आशियाई राष्ट्रांमध्ये होण्याचा अंदाज आहे. या प्रदेशांमध्ये आधीच ‘एएमआर’ची वाढ पाहायला मिळाली आहे. “हे निष्कर्ष अधोरेखित करतात की, एएमआर हा अनेक दशकांपासून जागतिक आरोग्यासाठी एक महत्त्वाचा धोका ठरत आहे आणि हा धोका दिवसागणिक वाढत चालला आहे,” असे मोहसेन नागवी यांनी निवेदनात म्हटले आहे.
हेही वाचा : तुम्हीही तासनतास बसून काम करता का? मग तुम्हाला होऊ शकतो डेड बट सिंड्रोम
यावर उपाय काय?
सर्वत्र अँटिबायोटिक्स औषधांचा वापर सुधारल्यास २०५० पर्यंत ९२ दशलक्ष लोकांचे जीवन वाचवण्यात यश येईल, असे अभ्यासात सुचवण्यात आले आहे. नावीन्यपूर्ण अँटिबायोटिक्सच्या निर्मितीला प्रोत्साहन देण्यासाठी अनेक सरकारे वेगवेगळ्या पद्धतींचे प्रयोग करीत आहेत. उल्लेखनीय बाब म्हणजे हा अभ्यास २६ सप्टेंबर रोजी होणाऱ्या संयुक्त राष्ट्रांच्या उच्चस्तरीय एएमआर बैठकीपूर्वी प्रसिद्ध करण्यात आला आहे. न्यू यॉर्क येथील संयुक्त राष्ट्रांच्या बैठकीत या समस्येवर बोलण्यासाठी जागतिक नेते एकत्र येतील. या बैठकीत ‘एएमआर’चा सामना करण्यासाठी काही राजकीय घोषणाही केल्या जातील. त्यात २०३० पर्यंत ‘एएमआर’शी संबंधित मृत्युदरात १० टक्के घट करण्याचे उद्दिष्ट समाविष्ट असेल.
